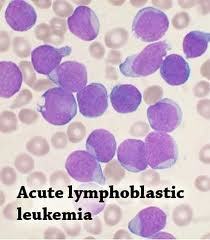

1
Q
Leukemia
A
- White Blood Cell cancer in the blood
2
Q
Leukemia
A
2 Presentations:
- Chronic
- Acute
3
Q
Chronic Leukemia
A
- Mature developed WBCs
- Look pretty normal in smear
- BUT More of them!
- In older patients
- Asymptomatic
- Elevated WBC Count 60-100!
4
Q
Differentials for Chronic Leukemia
A
- Smear will look pretty normal, but look for:
- Neutrophils =
- Chronic myelogenous leukemia
- (CML)
- Chronic myelogenous leukemia
- Lymphocytes =
- Chronic Lymphocytic Leukemia
- (CLL)
- Chronic Lymphocytic Leukemia
- Neutrophils =
- Confirm Dx w/ Bone Marrow Biopsy!
5
Q
Chronic myelogenous leukemia
(CML)
A
- Disease of Middle Age
- Present w/ chronic picture
- Elevated White Count
- Asymptomatic
- Differential:
- Neutrophils predominate
- Bx: t(9:22) = Philadelphia Chromosome
- Tyrosine Kinase
- Need to treat w/ Imatinib
- B/c Tyrosine Kinase inhibitor
- These patients will undergo Blast Crisis = no good.
6
Q
Chronic Myelogenous Leukemia
(CML)
Treatment
A
- Responds to
- Imatinib (chemo)
- Tyrosine kinsae inhibitor
- Imatinib (chemo)

7
Q
Chronic Lymphocytic Leukemia
(CLL)
Treatment Options
A
- Responds to:
- Nothing
- If pt. 65+ and no donor
- Can do Chemo for these pts
- Reassure, watch, wait for symptoms
- Chemo
- Stem Cell Transplant
- Younger patient, w/ donor
- Nothing
8
Q
Acute Leukemias
A
- Blasts: Big ugly cells that are not mature
- Lots of cytoplasms, little nucleus
- Symptomatic!!!
- Anemia
- Bleeding
- Fevers
- Infections
- Bone Pain
- Lots of WBCs, crowd out Marrow
- More Agressive
- Patients are Younger
- *
9
Q
Acute Leukemias
A
- Look at Smears:
- Acute Myelogenous Leukemia
- Neutrophils
- Acute Lymphocytic Leukemia
- Lymphs
- Acute Myelogenous Leukemia
*Get Bone Marrow Bx
10
Q
Acute Myelogenous Leukemia
(AML)
A
- Neutrophils
- Blasts, not developed
- Average pt. age: 27yo
- Need exposure to get:
- Benzene,
- or past Chemo/Radiation
- or former CML w/ Blast Crisis
Dx: Smear then Bone Marrow bx (+myeloperoxidase)

11
Q
Acute Myelogenous Leukemia
(AML)
Treatment
A
- +M3 (Auer Rods)
- Use Vit. A
- If not M3
- Use Chemo
12
Q
Acute Lymphocytic Leukemia
(ALL)
A
- Blastic, immature Lymphocytes
- Young patients; childhood disease (~7yo)
- Acute presentation
- Dx: Blood Smear, then Bone Marrow Bx
- need 20% Blasts!
- cALLa, or
- Tdt
13
Q
Acute Lymphocytic Leukemia
(ALL)
Treatment
A
- Treat with Chemo
- prophylaxis CNS with Ara-C
- B/c ALL is in CNS
14
Q
Chronic Lymphocytic Leukemia
(CLL)
A
- Predominately Lymphocytes
- No blasts (b/c not acute!)
- Found in Elderly!
- Asymptomatic
- Elevated WBC count
- Differential:
- Predominately Lymphocytes
- Test: Bone Marrow Biopsy
- “Patients die with it, not from it”
15
Q
Let’s Drive it Home….
A
- Acute = Blasts! & Get a Smear!
- Chronic = No Blasts! & Get a Diff!
- ALL = Kids; Prophylaxis CNS
- AML = Teens & 20s; M3 variant?
- CML = Middle-aged; Philly chromosome; Imatinib
- CLL = Elderly; watch & wait? stem cell? Chemo?


